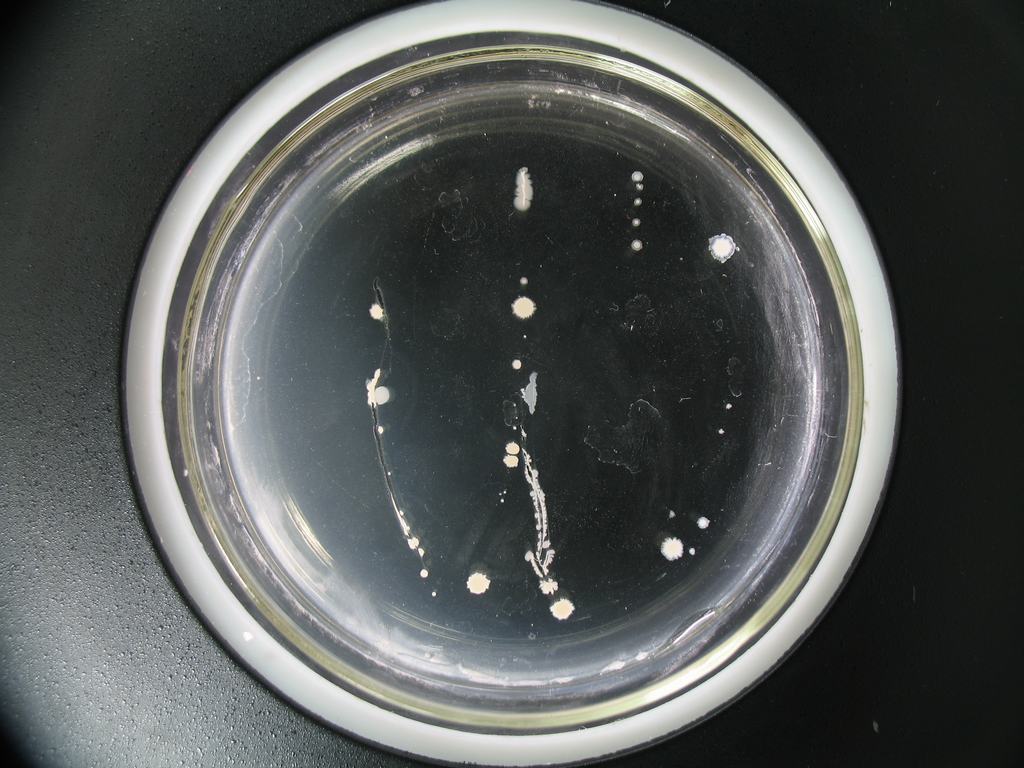
红酵母属

红酵母菌

粘红酵母
图片尺寸640x480
生产供应海洋红酵母红酵母富含胡萝卜素虾青素
图片尺寸400x304
酿酒酵母形态特征微生物孟加拉红
图片尺寸1197x1200
极具开发价值的酵母菌 ——胶红酵母
图片尺寸640x480
大红菌怎么分有毒没毒
图片尺寸600x600
科学时报 >正文 美国科学家利用酵母菌对基因表达的进化进行了研究.
图片尺寸347x334
红酵母属
图片尺寸1024x768
海洋红酵母菌粉
图片尺寸274x308
红酵母属
图片尺寸1024x768
产类阿片样活性小肽的胶红酵母菌,其筛选方法及其应用与流程
图片尺寸948x954
请问这种红色菌是否能食用
图片尺寸500x742
霉菌,酵母检测问题(孟加拉红培养基)
图片尺寸1552x2592
胡超群研究团队与诺晶生物就圆红冬孢酵母菌及其应用达成专利合作
图片尺寸821x374
云南省普洱太阳河国家公园的红菌
图片尺寸1136x757
红酵母属
图片尺寸1024x768
红菌的营养价值有哪些
图片尺寸1000x830
胶红酵母 sicc 2.506
图片尺寸640x425
海洋红酵母
图片尺寸1440x1080
红酵母
图片尺寸212x230
酵母菌在孟加拉红琼脂(虎红琼脂)上的典型特征为红色菌落
图片尺寸2288x1712